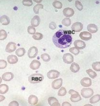

generalidades en el abordaje de las anemias Flashcards
disminucion en la capacidad de la sangre para transportar oxigeno a los tejidos, lo que provoca hipoxia
anemia
disminucion en la concentracion de hemoglobina
anemia
padecimiento hematologico mas frecuene
anemia
variables para el nivel de hemaglobina en sangre
- edad
- sexo
- altura sobre nivel del mar
hemoglobina en recien nacidos
16.5 gr/dl
las anemias se pueden clasificar en:
- regenerativas o arregenerativas
- agudas o cronicas
- hereditarias o adquiridas
la mayoria de las anemias son (regenerativas/arregenerativas)
arregenerativas
valor de indice de reticulocitos en anemias regenerativas
mayor a 2%
valor de indice de reticulocitos en anemias arregenerativas
mayor a 1%
V/F: los recién nacidos tienen más hemoglobina y hematocrito
verdaderp
en qué consiste la prueba de Coombs?
se realiza cuando un recien nacido presenta hemolisis; si es positiva indica una hemólisis autoinmune por incompatibilidad al grupo rh
una anemia aguda por algún sangrado es (regenerativa/arregenerativa)
regenerativa
causas de anemias en general
- deficiencia de hierro (38%)
- insuficiencia renal (26%)
- procesos malignos (18%)
- infeccion (7%)
- hemorragia (3%)
- desnutricion (7%)
- anemia hemolitica (1%)
en bebes menores de 30 meses la anemia es mas comun en (niños/niñas)
niños
causas de anemia en bebes menores de 30 meses
- hipocromia (54%)
- infeccion (22%)
- prematurez (12%)
- desnutricion (4%)
- procesos malignos (4%)
- hemoliticos (2%)
casuas de anemia en preescolares
- hipocromicas (28%)
- infeccion (22%)
- procesos malignos (23%)
causas de anemia en escolares
- procesos malignos (28%)
- insuficiencia renal (19%)
- hipocromicas (18%)
- refractarias (15%)
- infeccion (10%)
qué es la concentracion relativa de Hb?
la masa de Hb en relacion con el volumen de plasma (puede haber mucho plasma y hacer parecer que el hematocrito esta bajo pero realmente esta normal)
qué es la concentracion absoluta de Hb?
es la masa total real de Hb indepediente del plasma
cuándo se produce anemia?
cuando la perdida o destruccion de los eritrocitos excede la capacidad maxima de la medula osea para su produccion o cuando esta perturbada la produccion de eritrocitos por la medula osea
la adaptacion a la anemia depende de:
- velocidad en el inicio de la perdida de sangre
- intensdad de la perdida de sangre
- capacidad del cuerpo para adaptarse a la Hb baja
clasificacion patogenica de las anemias (por su fisiopatologia)
- alteracion en el estimulo eritropoyetico (por endocrinopatia o insuficiencia renal)
- lesion de MO
- deficiencia de nutrientes
- perdida sanguinea o sobrevida disminuida
cuadro clinico de una anemia lenta y gradual
- manifestacion de hipoxia y compensacion
- aumento de 2,3 DPG
cuadro clinico de una anemia por instalacion subita
- manifestacion de hipovolemia
- choque